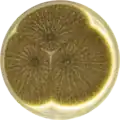
Aspergillus neoniger growing on CYA plate

Aspergillus neoniger
| Aspergillus neoniger | |
|---|---|
| Scientific classification | |
| Kingdom: | Fungi |
| Division: | Ascomycota |
| Class: | Eurotiomycetes |
| Order: | Eurotiales |
| Family: | Aspergillaceae |
| Genus: | Aspergillus |
| Species: | A. neoniger
|
| Binomial name | |
| Aspergillus neoniger Varga, Frisvad & Samson (2011)[1]
| |
Aspergillus neoniger is a species of fungus in the genus Aspergillus. It belongs to the group of black Aspergilli which are important industrial workhorses.[2][3][4] A. neoniger belongs to the Nigri section. The species was first described in 2011.[1] The species was isolated from desert sand in Namibia and mangrove water in Venezuela. A. neoniger produces aurasperone B and pyranonigrin A.[1]
The genome of A. neoniger was sequenced and published in 2014 as part of the Aspergillus whole-genome sequencing project – a project dedicated to performing whole-genome sequencing of all members of the genus Aspergillus.[5] The genome assembly size was 35.42 Mbp.[5]
Growth and morphology
Aspergillus neoniger has been cultivated on both Czapek yeast extract agar (CYA) plates and Malt Extract Agar Oxoid® (MEAOX) plates. The growth morphology of the colonies can be seen in the pictures below.
-
Aspergillus neoniger growing on CYA plate
Aspergillus neoniger growing on CYA plate -
 Aspergillus neoniger growing on MEAOX plate
Aspergillus neoniger growing on MEAOX plate
References
- ^ a b c Varga, J.; Frisvad, J. C.; Kocsubé, S.; Brankovics, B.; Tóth, B.; Szigeti, G.; Samson, R. A. New and revisited species in Aspergillus section Nigri. Stud. Mycol. 2011, 69, 1–17, doi:10.3114/sim.2011.69.01.
- ^ Pel, H. J.; de Winde, J. H.; Archer, D. B.; Dyer, P. S.; Hofmann, G.; Schaap, P. J.; Turner, G.; de Vries, R. P.; Albang, R.; Albermann, K.; Andersen, M. R.; Bendtsen, J. D.; Benen, J. A. E.; van den Berg, M.; Breestraat, S.; Caddick, M. X.; Contreras, R.; Cornell, M.; Coutinho, P. M.; Danchin, E. G. J.; Debets, A. J. M.; Dekker, P.; van Dijck, P. W. M.; van Dijk, A.; Dijkhuizen, L.; Driessen, A. J. M.; d’Enfert, C.; Geysens, S.; Goosen, C.; Groot, G. S. P.; de Groot, P. W. J.; Guillemette, T.; Henrissat, B.; Herweijer, M.; van den Hombergh, J. P. T. W.; van den Hondel, C. A. M. J. J.; van der Heijden, R. T. J. M.; van der Kaaij, R. M.; Klis, F. M.; Kools, H. J.; Kubicek, C. P.; van Kuyk, P. A.; Lauber, J.; Lu, X.; van der Maarel, M. J. E. C.; Meulenberg, R.; Menke, H.; Mortimer, M. A.; Nielsen, J.; Oliver, S. G.; Olsthoorn, M.; Pal, K.; van Peij, N. N. M. E.; Ram, A. F. J.; Rinas, U.; Roubos, J. A.; Sagt, C. M. J.; Schmoll, M.; Sun, J.; Ussery, D.; Varga, J.; Vervecken, W.; van de Vondervoort, P. J. J.; Wedler, H.; Wösten, H. A. B.; Zeng, A.-P.; van Ooyen, A. J. J.; Visser, J.; Stam, H. Genome sequencing and analysis of the versatile cell factory Aspergillus niger CBS 513.88. Nat. Biotechnol. 2007, 25, 221–231, doi:10.1038/nbt1282.
- ^ Goldberg, I.; Rokem, J. S.; Pines, O. Organic acids: old metabolites, new themes. Journal of Chemical Technology & Biotechnology 2006, 81, 1601–1611, doi:10.1002/jctb.1590.
- ^ Pariza, M. W.; Foster, E. M. Determining the Safety of Enzymes Used in Food Processing. Journal of Food Protection 1983, 46, 453–468, doi:10.4315/0362-028X-46.5.453.
- ^ a b "Home - Aspergillus neoniger CBS 115656 v1.0". genome.jgi.doe.gov.